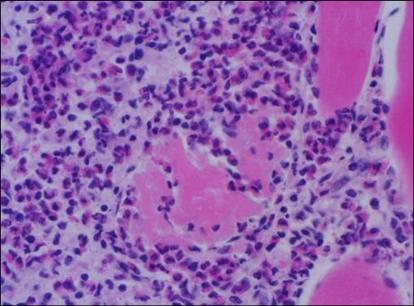
https://cdn.ncbi.nlm.nih.gov/pmc/blobs/baac/2811786/dd6990637c3a/jvs-9-425-g003.jpg

一头屠宰的韩国本土牛的嗜酸性肌炎
Eosinophilic myositis in a slaughtered Korean native cattle.
作者信息
Do Sun Hee, Jeong Da Hee, Chung Jae Yong, Park Jin Kyu, Yang Hai Jie, Yuan Dong Wei, Jeong Kyu Shik
机构信息
Department of Veterinary Pathology, College of Veterinary Medicine, Kyungpook National University, Daegu 702-701, Korea.
出版信息
J Vet Sci. 2008 Dec;9(4):425-7. doi: 10.4142/jvs.2008.9.4.425.
Histopathological findings of eosinophilic myositis in the carcass of a slaughtered Korean native cow are presented. Lesions contained massive fibrous septae with vacuolar changes in some lesions, and the hypercontraction and rupturing of muscle bundles, with replacement by eosinophils. Necrosis and severe eosinophil infiltration were observed. Sarcoplasmic fragmentation and atrophy developed. Typical of granuloma, calcified myofibers were focally surrounded by macrophages and numerous inflammatory cells, and multinucleated giant cell formation was evident.
本文展示了一头屠宰的韩国本土牛尸体中嗜酸性肌炎的组织病理学发现。病变包含大量纤维间隔,部分病变有液泡样改变,肌束过度收缩和断裂,并有嗜酸性粒细胞替代。观察到坏死和严重的嗜酸性粒细胞浸润。出现了肌浆断裂和萎缩。典型的肉芽肿表现为钙化的肌纤维局部被巨噬细胞和大量炎性细胞包围,多核巨细胞形成明显。